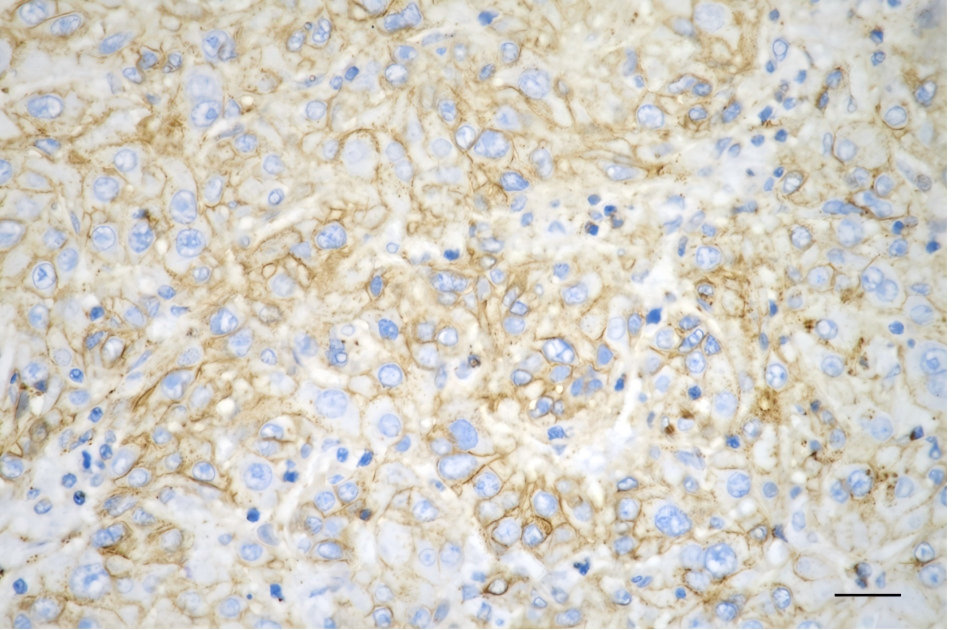

FLOT1 Recombinant Monoclonal Antibody
-
中文名稱:FLOT1 Recombinant Monoclonal Antibody
-
貨號:CSB-RA058742A0HU
-
規格:¥1320
-
圖片:
-
Flow cytometric analysis of Flotillin1 expression in HepG2 cells using Flotillin1 antibody. Green, isotype control; red, Flotillin1.
-
Immunocytochemical staining of HepG2 cells with Flotillin 1 antibody. Nuclei were stained blue with DAPI; Flotillin 1 was stained magenta with Alexa Fluor? 647. Images were taken using Leica stellaris 5. Protein abundance based on laser Intensity and smart gain: Medium. Scale bar, 20 μm.
-
Immunohistochemistry was performed on paraffin-embedded human hepatocarcinoma using flotillin 1 antibody. Antigen retrieval was done in sodium citrate buffer (pH 6.0). DAB was used for detection, with hematoxylin counterstaining. Images were acquired using a Nikon Ci-L Plus microscope (40× objective). Scale bar: 25 μm.
-
Western blotting analysis using flotillin 1 antibody. Total cell lysates (30 μg for H9c2, 20 μg for others) from various cell lines were loaded and separated by SDS-PAGE. The blot was incubated with flotillin 1 antibody and HRP-conjugated goat anti-rabbit secondary antibody respectively.
-
-
其他:
產品詳情
-
Uniprot No.:
-
基因名:
-
別名:FLOT1; Flotillin 1; Flotillin-1; Integral Membrane Component Of Caveolae
-
反應種屬:Human, Mouse, Rat
-
免疫原:Recombinant Human FLOT1 protein
-
免疫原種屬:Homo sapiens (Human)
-
標記方式:Non-conjugated
-
克隆類型:Monoclonal
-
抗體亞型:Rabbit IgG
-
純化方式:Affinity-chromatography
-
克隆號:25A4
-
濃度:It differs from different batches. Please contact us to confirm it.
-
保存緩沖液:Rabbit IgG in PBS (pH 7.4) containing 50% glycerol, and 0.02% sodium azide.
-
產品提供形式:Liquid
-
應用范圍:ELISA, WB, FC, ICC, IHC
-
推薦稀釋比:
Application Recommended Dilution WB 1:2000-1:10000 FC 1:200-1:2000 ICC 1:100-1:1000 IHC 1:100-1:200 -
Protocols:
-
儲存條件:Upon receipt, store at -20°C or -80°C. Avoid repeated freeze.
-
貨期:Basically, we can dispatch the products out in 1-3 working days after receiving your orders. Delivery time maybe differs from different purchasing way or location, please kindly consult your local distributors for specific delivery time.
-
用途:For Research Use Only. Not for use in diagnostic or therapeutic procedures.
相關產品
靶點詳情
-
功能:May act as a scaffolding protein within caveolar membranes, functionally participating in formation of caveolae or caveolae-like vesicles.
-
基因功能參考文獻:
- flotillin-1 is a tumorigenic protein that plays an important role in promoting the proliferation and tumorigenicity of LUAD. PMID: 28825855
- flotillin has a role in desmosomal adhesion and Pemphigus vulgaris-like localisation of desmoglein-3 in human keratinocytes PMID: 27346727
- Autoantibodies against flotillin-1/2 heterocomplex are present in 1-2% of patients with bona fide multiple sclerosis. PMID: 28645295
- Furthermore, we identify flotillin-1 (FLOT1) and histone H1 as downstream factors for cytoplasmic and nuclear pathway of S100A11, which are required for LASP1-S100A11 axis-mediated epithelial-mesenchymal transition and colorectal cancer progression. PMID: 27181092
- FLOT1 is associated with aggressive characteristics of HCC PMID: 23840303
- This study presents the endocytic pathways of internalization for muscarinic type 3 receptor and flotillin-1/2 in salivary gland epithelial cells. knockdown of flot-1 or -2 by flotillin-specific siRNA prevented internalization and reduced the endocytic efficiency of muscarinic type 3 receptor. PMID: 27221048
- Data show that overexpression of 4.1N protein decreased expression of flotillin-1, decreased activation of beta-catenin/Wnt pathway in non-small-cell lung cancer (NSCLC) cells. PMID: 27448302
- Upregulation of flotillin-1 promotes invasion and metastasis by activating TGF-beta signaling in nasopharyngeal carcinoma. PMID: 26646322
- Flotillin-1 protein is upregulated in human endometrial cancer and localization shifts from epithelial to stromal with increasing tumor grade PMID: 26682635
- Expression of flotillin-1 was associated with H-Ras in breast cancer, especially in TNBC (p < 0.001). PMID: 26413934
- findings revealed the expression of flotillin 1 in gastric cancer samples is significantly higher than that of noncancer/normal tissues; findings suggest that flotillin 1 may be a novel biomarker for gastric cancer PMID: 25948494
- miR-506 expression was down-regulated in clear cell renal cell carcinoma (ccRCC) and correlated with advanced histologic grade, clinical stage, tumor stage, positive lymph node metastasis, and distant metastasis. FLOT1, a potential target gene of miR-506, was inversely correlated with miR-506 expression in ccRCC tissues. PMID: 25793370
- polycystins are necessary for assembly of a novel flotillin-containing ciliary signaling complex and provide a molecular rationale for the common renal pathologies caused by OFD1 and polycystin mutations. PMID: 25180832
- Findings suggest that FLOT1 plays an important role in the proliferation and recurrence of transitional cell carcinoma. PMID: 24890092
- Downregulation of microRNA-182-5p contributes to renal cell carcinoma proliferation via activating the AKT/FOXO3a signaling pathway with FLOT1 being a target. PMID: 24886554
- overexpression of FLOT1 can be found in tongue squamous cell cancer patients with higher pathological stage, T classification, N classification or recurrence PMID: 24695539
- Flotillin-1 mRNA expression is up-regulated in non-small cell lung cancer patients. PMID: 24533441
- a critical role of flotillin-1 in ROS production mediated by c-Src PMID: 24983503
- Flotillin-1 regulates oncogenic signaling in neuroblastoma cells by regulating ALK membrane association. PMID: 24830726
- The FLOT1 is abundantly expressed in term villous placental CTs and endothelial cells, and in comparison, expression of these proteins in the ST is reduced. PMID: 23064789
- Depletion of either flotillin-1 or flotillin-2 resulted in downregulation of ErbB3 and a selective reduction of ErbB2-ErbB3 receptor complexes. PMID: 24747692
- study demonstrated that miR-124 might be a tumor suppressor in breast cancer via the regulation of FLOT1 PMID: 24330780
- We have identified flotillin 1 and 2 as new partners of the cadherin complexes PMID: 24046456
- These data here provide direct evidences for the molecular interaction and endocytosis of PrP(C) with Flot-1 in the presence of copper ions. PMID: 23625312
- Patients with higher FLOT1 expression had shorter overall survival time, whereas those with lower FLOT1 expression had longer survival time PMID: 24277378
- Human group V secretory phospholipase A2 is associated with lipid rafts and internalized in a flotillindependent pathway. PMID: 24042857
- EGFR overexpression and increase in signaling correlates with flotillin-1 expresion. PMID: 24304721
- Report role for flotillin 1/2 in interactions of lung epithelial cells with silica nanoparticles. PMID: 22669515
- we describe how flotillin-1 and -2 contribute to the stabilization of ErbB2 at the cell surface in breast cancer tissue PMID: 22869152
- Flotillin-1 plays an important role in Oral squamous cell carcinoma (OSCC) development. PMID: 23581411
- Flotillin-1 interacted with PrPc and promote the endocytosis of PrPc. PMID: 23627023
- results support predominant formation of flotillin-1 and -2 hetero-oligomers in resting and chemokine-stimulated human T-cells which may importantly contribute to structuring of the uropod. PMID: 23012365
- a novel signaling network containing FRS2, CAP and flotillin-1 PMID: 22235335
- receptor-tyrosine kinases may also rely on flotillin-1 upon activation, thus suggesting a general role for flotillin-1 as a novel factor in receptor-tyrosine kinase/MAP kinase signaling. PMID: 22232557
- Chlamydia pneumoniae intracellular growth was attenuated in the flotillin-1-silenced cells. PMID: 22215737
- FLOT1 plays an important role in promoting proliferation and tumorigenesis of human breast cancer and may represent a novel prognostic biomarker and therapeutic target for the disease. PMID: 21447726
- Flot1-enriched membrane microdomains are required for protein kinase C-regulated internalization of the DA transporter (DAT) and the glial glutamate transporter EAAT2. PMID: 21399631
- flotillins have a role in NPC1L1-mediated cholesterol uptake and NPC1L1-flotillins-postive cholesterol-enriched membrane microdomains are involved in the mechanism for efficient cholesterol absorption PMID: 21187433
- the cellular pathways used by transportan and transportan 10 (TP10) for protein transduction PMID: 19348413
- Data show that the BCG phagosome is relatively depleted in LAMP-2, NPC1, flotillin-1, vATPase, and syntaxin 3. PMID: 19815536
- In hematopoietic cells, flotillins provide intrinsic cues that govern segregation of certain microdomain-associated molecules during immune cell polarization. PMID: 20027317
- Flotillin-1, a marker of rafts, accumulates in lysosomes of neurons in Alzheimer's disease PMID: 14708344
- ATP-binding cassette, sub-family A (ABC1), member 1 forms a complex with syntaxin 13 and flotillin-1, residing at the plasma membrane and in phagosomes PMID: 15469992
- It is significant that there is an increased gene expression of flotillin-1 in the Parkinson substantia nigra/ventral tegmental area compared to controls. PMID: 15545008
- Recombinant flotillin-1 was purified and characterized in in large quantity and high purity. PMID: 15939299
- Myocilins with mutations such as G364V, K423E, and Y437H on the domain failed to interact with flotillin-1. PMID: 16198165
- Flotillin-1 small interfering RNA (siRNA) inhibited both clathrin-independent uptake of cholera toxin and endocytosis of a GPI-linked protein. We propose that flotillin-1 is one determinant of a clathrin-independent endocytic pathway in mammalian cells. PMID: 16341206
- flotillin-1 may recruit amyloid beta (A4) precursor protein to lipid rafts and therefore participate in the localization and processing of APP PMID: 16480949
- The results showed that flotillin-1 can interact with arginase1, and hence arginase activity was up-regulated by 26.8%. PMID: 17113085
- These lines of evidence suggested that a Gq-coupled receptor activates specifically p38 MAPK through lipid rafts and Src kinase activation, in which flotillins positively modulate the Gq signaling. PMID: 17307333
顯示更多
收起更多
-
亞細胞定位:Cell membrane; Peripheral membrane protein. Endosome. Membrane, caveola; Peripheral membrane protein. Melanosome. Membrane raft.
-
蛋白家族:Band 7/mec-2 family, Flotillin subfamily
-
數據庫鏈接:
Most popular with customers
-
-
YWHAB Recombinant Monoclonal Antibody
Applications: ELISA, WB, IHC, IF, FC
Species Reactivity: Human, Mouse, Rat
-
Phospho-YAP1 (S127) Recombinant Monoclonal Antibody
Applications: ELISA, WB, IHC
Species Reactivity: Human
-
-
-
-
-